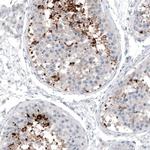
CT83 Antibody in Immunohistochemistry (IHC)

Search
Invitrogen
CT83 Monoclonal Antibody (CL4762)
{{$productOrderCtrl.translations['antibody.pdp.commerceCard.promotion.promotions']}}
{{$productOrderCtrl.translations['antibody.pdp.commerceCard.promotion.viewpromo']}}
{{$productOrderCtrl.translations['antibody.pdp.commerceCard.promotion.promocode']}}: {{promo.promoCode}} {{promo.promoTitle}} {{promo.promoDescription}}. {{$productOrderCtrl.translations['antibody.pdp.commerceCard.promotion.learnmore']}}

Please note: We are reviewing Western blot images included in the antibody testing data in our catalog, including those provided by third parties. Unless expressly labeled or annotated as “raw-unedited”, Western blot images included in the antibody testing data in our catalog may have been edited, optimized or otherwise adjusted for presentation.
产品信息
MA5-24711
种属反应
已发表种属
宿主/亚型
分类
类型
克隆号
偶联物
形式
浓度
规格
纯化类型
保存液
内含物
保存条件
运输条件
RRID
产品详细信息
Immunogen sequence: QRNTGEMSSNS TALALVRPSS SGLINSNTDN NLAVYDLSRD ILNNFPHSIA RQKRILVNLS MVENKLVELE HTLLSKGFRG ASPHRKST
Binds to an epitope located within the peptide sequence STALALVRPSSSGLI as determined by overlapping synthetic peptides.
Highest antigen sequence identity to the following orthologs - mouse 30%, rat 30%.
靶标信息
CT83 is a protein coding gene.
仅用于科研。不用于诊断过程。未经明确授权不得转售。
生物信息学
蛋白别名: Cancer/testis antigen 83; Kita-kyushu lung cancer antigen 1; KK-LC-1
基因别名: CT83; CXorf61; KKLC1
Entrez Gene ID: (Human) 203413




